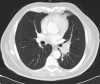

El acceso a Neurorecordings está restringido a médicos, y hace uso del sistema de validación de la plataforma Navandú. Si aún no dispone de usuario es necesario proceder previamente a su registro.
Para cualquier consulta puede dirigirse al Centro de Atención Navandú.
Para iniciar sesión y registrarse en Neurorecordings, le vamos a redirigir a la plataforma de validación profesional de Navandu.
AVISO
Está saliendo del sitio web de Neurorecordings. Este enlace le llevará a un sitio web en el que no se aplica nuestra Política de Privacidad. Usted es el único responsable de sus interacciones con ese sitio web.